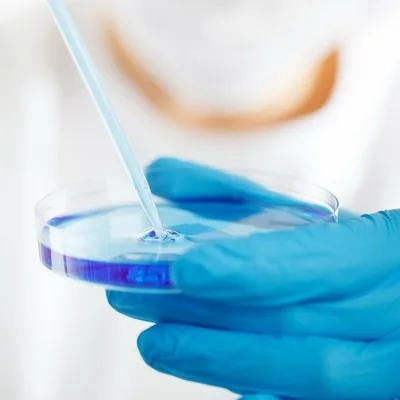
IVF-Zentrum Esslingen

Best IVF and Fertility Clinics in Lingen
Clinics with the highest ratings and verified quality care in this region.
Top IVF Clinics in Lingen
Clinics with the highest ratings and verified quality care in this region.
Other Destinations in Germany
Explore other popular destinations in Germany.
Explore IVF Clinics by Country
United States(916)France(887)Germany(851)Spain(746)Poland(636)Italy(535)United Kingdom(521)Japan(463)Ukraine(432)Brazil(308)Romania(254)Mexico(236)Netherlands(193)Oman(188)Indonesia(162)Philippines(144)Hungary(139)Serbia(132)Greece(121)Belgium(120)Sweden(110)Portugal(103)Bulgaria(99)Canada(97)Belarus(81)Finland(81)Austria(72)Switzerland(72)Moldova(71)Turkey(69)Norway(67)Albania(66)Denmark(61)Bosnia and Herzegovina(60)Argentina(60)Croatia(58)Ireland(56)Colombia(56)Slovakia(52)Lithuania(46)